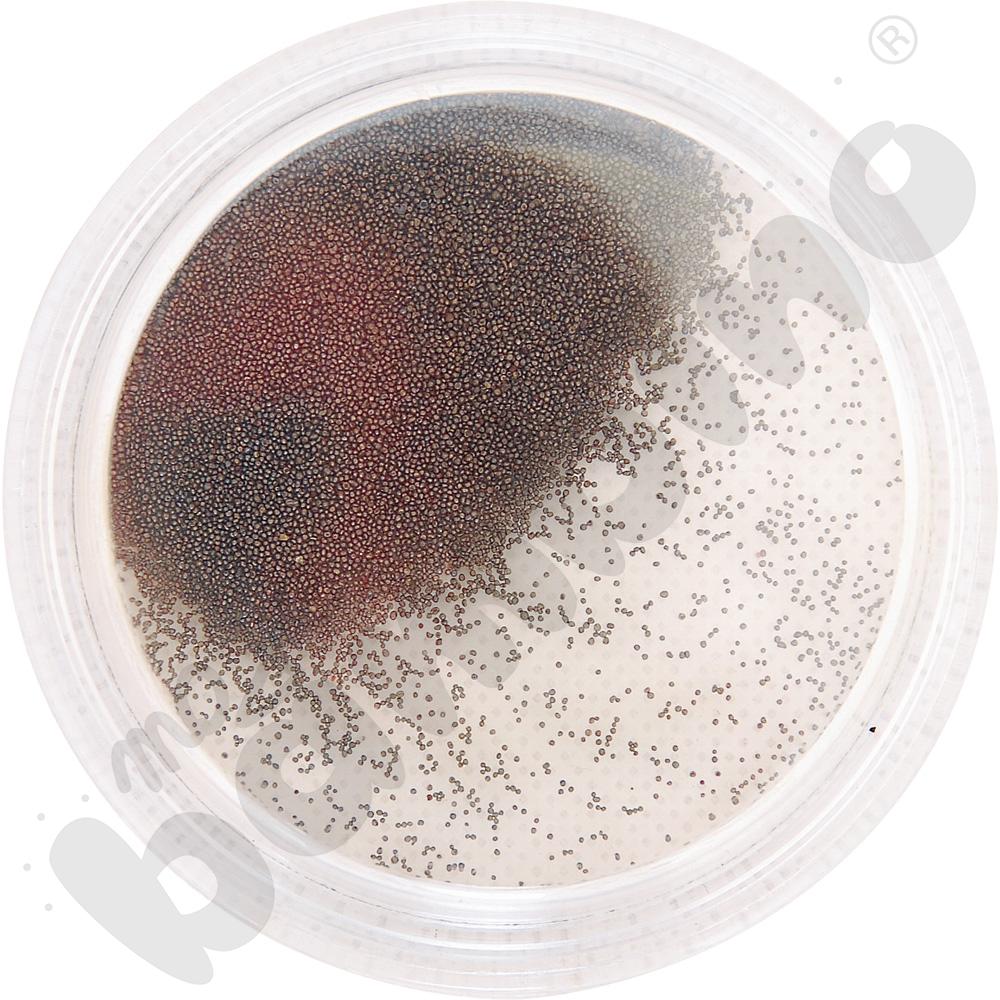
Pudełka z opiłkami ferromagnetycznymi, 10 szt.

Filtruj według
Filtry

Masz jakieś pytania?


Pomoce naukowe do badania magnetyzmu w szkole podstawowej
Pomoce naukowe do szkoły podstawowej, które klienci mogą znaleźć w ramach przygotowanej przez nas oferty, to wysokiej jakości produkty. Zostały one opracowane w oparciu o potrzeby dzieci w wieku szkolnym oraz oczekiwania pedagogów, którzy dzięki odpowiednio dobranym artykułom pomocniczym będą w stanie prowadzić interesujące lekcje fizyki. Wśród oferowanych rozwiązań znalazły się między innymi zestawy do testowania materiałów magnetycznych, przyrządy do demonstracji pola magnetycznego, magnesy neodymowe czy Pociągi Elektromagnetyczne. Te oraz wiele innych narzędzi pozwoli na badanie magnetyzmu, które stanie się dla dzieci o wiele prostsze oraz niezwykle fascynujące.
Szkoła podstawowa to czas, w którym uczniowie po raz pierwszy stykają się z fizyką. Nie jest to łatwy przedmiot, jednak - jak w wielu przypadkach - wszystko zależy od sposobu przekazywania informacji. Jeżeli wszelkie tłumaczone zależności będą odpowiednio zobrazowane, fizyka stanie się nie tylko o wiele prostsza, ale również bardzo ciekawa.
Jesteśmy sklepem internetowym, który koncentruje się na uczniach, nauczycielach, rodzicach oraz ich zróżnicowanych potrzebach i oczekiwaniach. Nasza oferta jest bogata w różnorodne propozycje i nieustannie wzbogacana o nowości. Przygotowane przez nas materiały do pracowni fizycznej umożliwiają nie tylko pomiary magnetyczne. Gwarantujemy również wiele innych narzędzi, które szybko odczarują nielubiany przez wielu uczniów przedmiot ścisły, jakim jest fizyka. Odpowiednie pomoce fizyczne pozwolą na wytłumaczenie trudnych zjawisk i oswojenie się z tą rozbudowaną dziedziną nauk przyrodniczych. Zachęcamy do bliższego przyjrzenia się przygotowanym przez nas rozwiązaniom do pracowni fizycznych.